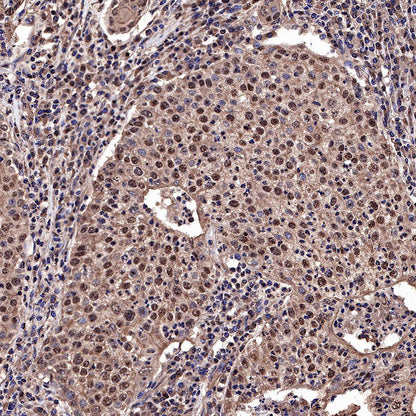

WB result of Ubiquitin Rabbit mAb
Primary antibody: Ubiquitin Rabbit mAb at 1/1000 dilution
Lane 1: untreated HT-1080 whole cell lysate 20 µg
Lane 2: HT-1080 treated with MG-132(10μM, 4h) whole cell lysate 20 µg
Secondary antibody: Goat Anti-Rabbit IgG, (H+L), HRP conjugated at 1/10000 dilution
Observed MW: 16~300 kDa
Product Details
Product Details
Product Specification
| Host | Rabbit |
| Antigen | Ubiquitin |
| Synonyms | N/A |
| Immunogen | N/A |
| Location | Cytoplasm, Nucleus |
| Accession | P62987 |
| Clone Number | SDT-R095 |
| Antibody Type | Recombinant mAb |
| Application | WB, IHC-P, ICC, ICFCM |
| Reactivity | Species Independent |
| Purification | Protein A |
| Concentration | 0.5 mg/ml |
| Physical Appearance | Liquid |
| Storage Buffer | PBS, 40% Glycerol, 0.05% BSA, 0.03% Proclin 300 |
| Stability & Storage | 12 months from date of receipt / reconstitution, -20 °C as supplied |
Dilution
| application | dilution | species |
| WB | 1:1000 | |
| IHC-P | 1:2000 | |
| ICFCM | 1:500 | |
| ICC | 1:500 |
Background
Protein ubiquitination is a dynamic multifaceted post-translational modification involved in nearly all aspects of eukaryotic biology. Once attached to a substrate, the 76-amino acid protein ubiquitin is subjected to further modifications, creating a multitude of distinct signals with distinct cellular outcomes, referred to as the 'ubiquitin code'. Ubiquitin can be ubiquitinated on seven lysine (Lys) residues or on the N-terminus, leading to polyubiquitin chains that can encompass complex topologies. Alternatively or in addition, ubiquitin Lys residues can be modified by ubiquitin-like molecules (such as SUMO or NEDD8). Finally, ubiquitin can also be acetylated on Lys, or phosphorylated on Ser, Thr or Tyr residues, and each modification has the potential to dramatically alter the signaling outcome [PMID: 27012465].
Picture
Picture
Western Blot


WB result of Ubiquitin Rabbit mAb
Primary antibody: Ubiquitin Rabbit mAb at 1/1000 dilution
Lane 1: untreated MCF7 whole cell lysate 20 µg
Lane 2: MCF7 treated with MG-132(10μM, 2h) whole cell lysate 20 µg
Secondary antibody: Goat Anti-Rabbit IgG, (H+L), HRP conjugated at 1/10000 dilution
Observed MW: 16~300 kDa

WB result of Ubiquitin Rabbit mAb
Primary antibody: Ubiquitin Rabbit mAb at 1/1000 dilution
Lane 1: NIH/3T3 whole cell lysate 20 µg
Secondary antibody: Goat Anti-Rabbit IgG, (H+L), HRP conjugated at 1/10000 dilution
Observed MW: 16~300 kDa

WB result of Ubiquitin Rabbit mAb
Primary antibody: Ubiquitin Rabbit mAb at 1/1000 dilution
Lane 1: C6 whole cell lysate 20 µg
Secondary antibody: Goat Anti-Rabbit IgG, (H+L), HRP conjugated at 1/10000 dilution
Observed MW: 16~300 kDa
FC

Flow cytometric analysis of 4% PFA fixed 90% methanol permeabilized C6 (Rat glial tumor glial cell) cells labelling Ubiquitin antibody at 1/500 dilution (0.1 μg) / (red) compared with a Rabbit monoclonal IgG (Black) isotype control and an unlabelled control (cells without incubation with primary antibody and secondary antibody) (Blue). Goat Anti - Rabbit IgG Alexa Fluor® 488 was used as the secondary antibody.
Immunohistochemistry




Immunocytochemistry

ICC shows positive staining in C6 cells. Anti-Ubiquitin antibody was used at 1/500 dilution (Green) and incubated overnight at 4°C. Goat polyclonal Antibody to Rabbit IgG - H&L (Alexa Fluor® 488) was used as secondary antibody at 1/1000 dilution. The cells were fixed with 100% ice-cold methanol and permeabilized with 0.1% PBS-Triton X-100. Nuclei were counterstained with DAPI (Blue). Counterstain with tubulin (red).